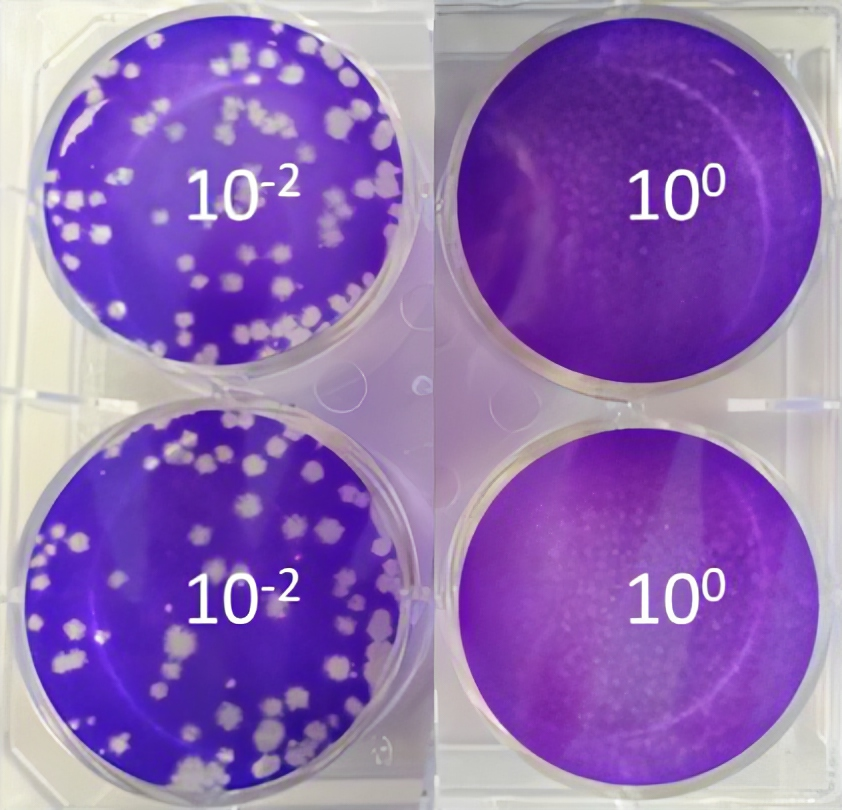

Research suggests changes to the homes and communities of the future

With COVID-19 changing the way that people live and work, new research from Marley has revealed what people value most about their homes and communities in post-lockdown Britain. Here, Stuart Nicholson, talks us through the findings and the implications for those designing and specifying new homes.
2020 was a year like no other, with COVID restrictions, furlough and health concerns forcing large numbers of people to spend long periods of time in their homes. The house had to become the gym, the office, the school, and the relaxation space, causing people to re-evaluate where they live, work and how they spend their time.